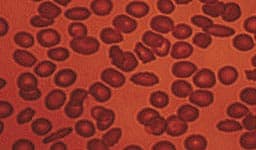

Life Extension Magazine®
The aging process damages blood vessels, even when conventional risk factors such as cholesterol and blood pressure are within normal ranges. Despite aggressive intervention with diet, exercise, supplements, and drugs, pathological changes still occur in the arterial wall that predispose aging adults to vascular diseases. The encouraging news is that a non-prescription method has been developed to address the underlying reason why arteries become occluded as people reach the later stages of their lives. For the past 35 years, the standard way to treat coronary atherosclerosis has been to bypass the blocked arteries. Recuperation from coronary bypass surgery can take months, and some patients are afflicted with lifetime impairments such as memory loss, chronic inflammation, and depression.1,2 The scientific literature reveals that atherosclerosis is associated with high blood levels of homocysteine, C-reactive protein, insulin, iron, low-density lipoprotein (LDL), and triglycerides, along with low levels of high-density lipoprotein (HDL) and testosterone. Optimizing blood levels of these substances can dramatically reduce heart attack and stroke risk.3-14 Prescribing a “statin” drug is what today’s doctors typically do to prevent and treat coronary atherosclerosis. Cholesterol and LDL, however, are only partial players in the atherosclerosis process. Mainstream cardiologists fail to appreciate that coronary atherosclerosis is a sign of systemic arterial dysfunction requiring aggressive therapy to correct. Health-conscious adults have grown impatient with doctors who do not translate research findings into improved therapies. More than ever before, people are taking responsibility for the health of their arteries by correcting as many of the known risk factors as possible.
Anatomy of the ArteryArteries are the blood vessels that bear the full force of each heartbeat. Laypeople often think of arteries as flexible tubes whose only function is to carry blood that flows continuously throughout the body. In reality, arteries are dynamic, functioning muscular structures that in good health expand and contract to facilitate circulation and maintain optimal blood pressure. The artery’s outer layer mostly consists of connective tissue and provides structural containment for the two layers beneath. The middle arterial area comprises elastic smooth muscle that provides the contractile strength to make possible the artery’s expansion and contraction with each heartbeat. The inner layer—known as the endothelium—consists of a thin area of endothelial cells whose integrity is crucial if atherosclerosis is to be prevented. A vital function of the endothelium is to form a barrier to prevent toxic substances in the blood from entering the elastic smooth muscle in the middle vessel wall. Another specialized function of the endothelium is to react to mechanical forces such as blood pressure and blood flow generated by the heart’s beating action. The endothelium releases substances into cells of the middle layer smooth muscle that changes the tone or firmness of the artery. When endothelial cells sense an injury, they produce signals that prompt smooth muscle cells in the middle arterial wall to change. These changes result in the smooth muscle cells moving toward the site of vascular injury, where they reposition themselves just beneath the endothelial cell layer. In reaction to injury, endothelial cells also produce substances that signal circulating blood cells to stick to the endothelium (instead of effortlessly flowing through the vessel). Atherosclerosis gradually forms in response to this initial injury to the endothelium.
Changes in the Aging EndotheliumAs we grow older, some of the specialized functions of our endothelial cells become blunted. The self-renewal process weakens. The endothelial barrier becomes leaky. Signals to the middle wall smooth muscle cells that regulate their function become altered. Smooth muscle cells behave as if in reaction to endothelial injury, migrating to the endothelium, where they multiply and produce matrix proteins that gradually occlude the blood vessel. The addition of these smooth muscle cells and matrix proteins within the sub-endothelial space results in thickening of the artery’s inner wall. In older arteries, the inner wall becomes a battleground where multiple reactions occur that are similar to the process of chronic injury. The inner wall dysfunction that occurs in the aging artery provides fertile soil for the seeds of atherosclerosis. All of these processes whereby normal endothelial function is compromised are collectively referred to as endothelial dysfunction. How Atherosclerosis DevelopsAtherosclerosis is so common in older adults that some experts used to think it was part of normal aging. An alternative view is that atherosclerosis is a disease process that takes advantage of changes that occur within the aging artery. The vascular aging process and atherosclerotic process influence each other and become intertwined as we age. The more severe vascular aging is, the easier it is for atherosclerosis to take hold. The more severe atherosclerosis is, the greater its impact on diseases associated with vascular aging, such as stroke and heart attack. Thus, it appears that with advancing age, atherosclerosis and the aging process combine forces. An often-used analogy for atherosclerosis is a “clogged pipe.” This misguided perception either leads to bypass surgery or a procedure in which the blocked coronary artery is forced opened with a balloon catheter (angioplasty) and a stent is implanted to keep the artery open. While these surgical procedures have become necessary for many people, the “clogged pipe” analogy is an inaccurate way to view the process of atherosclerosis. Atherosclerosis begins with changes in endothelial cell function that cause white blood cells moving through the blood to stick to the endothelium instead of flowing by normally. The endothelium becomes weakened, which allows blood cells and toxic substances circulating in the blood to pass through the endothelium and enter the artery’s sub-endothelial compartment. Lipid or fat cell-like substances in the blood, such as LDL and triglycerides, then accumulate in this area.
The lipids that accumulate in the broken endothelium become oxidized. This causes them to signal the endothelial cells, which then alert smooth muscle cells to begin a “repair” process that eventually results in an atherosclerotic lesion. Depending on a person’s individual risk factors (such as poor diet, lack of exercise, smoking, high blood pressure, and the aging process itself), fat accumulation continues and the atherosclerotic process accelerates. White blood cells called macrophages then invade the area to digest the fat. Smooth muscle cells that have migrated to the area have already changed their nature to also scavenge fat. These fat-laden white blood cells and smooth muscle cells, which are called “foam cells,” induce chronic inflammatory attack by various immune components. Smooth muscle cells try to curtail the injury to the endothelium by producing collagen, which forms a cap over the injury site. Then calcium accumulates and forms a material resembling bone. This is why atherosclerosis used to be referred to as “hardening of the arteries.” This complex array of foam cells, calcification, and lipid accumulation is called an atherosclerotic plaque. The plaque grows, and if it becomes unstable, is vulnerable to acute rupture that exposes its contents to the blood. Platelets can then rapidly accumulate around this ruptured plaque, resulting in a blockage (or blood clot) on the inner surface of the blood vessel wall. This clot can become very large and occlude the vessel. Even small plaques, if they rupture, can interfere with blood flow and cause an acute heart attack. Alternatively, atherosclerotic plaques can enlarge to such a degree as to completely block blood flow. When blood flow within an artery is severely compromised by a large plaque or blood clot, the cells of tissues that depend on blood flow from that artery become damaged or die. Coronary atherosclerosis cuts off the heart’s blood supply by occluding the heart’s arteries, thus stopping the oxygen supply to the heart and causing a heart attack. A stroke results when atherosclerosis processes cut off the oxygen supply to a portion of the brain.
The Arterial Wall Under AttackHigh blood pressure, elevated LDL and triglycerides, low HDL, cigarette smoking, diabetes, obesity, and lack of exercise contribute to endothelial dysfunction and the subsequent development of atherosclerosis.15-25 Additional endothelial-damaging factors include excess levels of glucose, insulin, iron, homocysteine, fibrinogen, and C-reactive protein, as well as low HDL and free testosterone (in men).3,9,10,24,26-28 Homocysteine is particularly dangerous because it can induce the initial injury to the endothelium. Homocysteine then facilitates oxidation of the fat/LDL that accumulates beneath the damaged endothelium, and finally contributes to the abnormal accumulation of blood components around the atherosclerotic lesion.29 Fibrinogen is a clotting factor that accumulates at the site of the endothelial lesion. Fibrinogen may contribute to plaque buildup or participate in blood clot-induced blockage of an artery after an unstable atherosclerotic plaque ruptures.30 Glucose at even high-normal levels may accelerate the glycation process that causes arterial stiffening, while high-normal fasting insulin inflicts direct damage to the endothelium.31-36 High levels of iron promote LDL oxidation in the damaged endothelium, while low levels of testosterone appear to interfere with normal endothelial function.9,11,14 C-reactive protein is not only an inflammatory marker, but also directly damages the endothelium. Chronic inflammation, as evidenced by persistent high levels of C-reactive protein, creates initial injuries to the endothelium and also accelerates the progression of existing atherosclerotic lesions.3,27 In response to numerous published studies, health-conscious people are altering their diets, taking drugs, hormones, and dietary supplements, and trying to exercise regularly in order to reduce these atherosclerosis risk factors. However, these efforts alone cannot be completely successful because age itself is a major risk factor for atherosclerosis. Atherosclerotic risk conferred by age is attributable in large measure to pathological endothelial dysfunction.37,38 As noted earlier, endothelial dysfunction is not synonymous with atherosclerosis, but the two processes are increasingly intertwined with advancing age.
| |||||||||||||
Maintaining Vascular Health During AgingEndothelial cells line the arteries, veins, arterioles, and capillaries of the vascular system. Twenty years ago, the endothelium was seen as a relatively inert structure that played no active role in vascular function. Since then, however, research has shown that the endothelium is dynamic and participates in vital aspects of arterial structure and function.39 Arterial blood vessel dilation depends on endothelial cells triggering the production of a signaling molecule called cyclic guanosine monophosphate (cyclic GMP) in the muscle cells. Cyclic GMP prompts a change in calcium flux at the smooth muscle cell surface, producing relaxation of the muscle. Relaxation of the artery muscle cells allows the artery to expand and then subsequently contract, helping to pump blood back to the heart.40 Nitric oxide production by endothelial cells also regulates vascular tone, changes cardiac contraction, prevents vessel injury, and helps prevent the development of atherosclerosis. Once atherosclerosis is present, however, endothelial cells cannot function properly, and this blocks nitric oxide-induced dilation, thus stiffening the arteries. The endothelium’s ability to manufacture enough nitric oxide to maintain artery dilation is one of its most crucial functions. When arteries lose their ability to respond to sudden increased demand for blood flow, endothelial dysfunction develops. This condition is a hallmark of cardiovascular disease. Endothelial dysfunction is also the earliest measurable functional abnormality of the vessel wall. Tests of endothelial dysfunction may detect abnormalities in the initial stages of atherosclerotic disease before clinical symptoms are present.40,41 In subjects with coronary artery disease, hypertension, and hypercholesteremia, endothelial dysfunction is always present.41 Furthermore, endothelial dysfunction is present in type I and type II diabetes, and is related to the development of diabetic vascular complications.41 Preventing endothelial dysfunction may be possible through innovative nutritional strategies. Emerging research suggests that propionyl-L-carnitine and PEAK ATP™ may protect cardiovascular health by preventing endothelial dysfunction, restoring healthy endothelial function, and optimizing the energy available to cardiac and vascular cells. PEAK ATP™ also works synergistically with propionyl-L-carnitine to protect cardiovascular function while promoting enhanced cellular energy for people with conditions ranging from chronic fatigue syndrome to erectile dysfunction.42,43 Propionyl-L-Carnitine (PLC)Research suggests that propionyl-L-carnitine (PLC) plays an important role in protecting the function and health of endothelial cells.44-46 Studies also indicate that PLC may act as a nutritional corrective agent, relieving clinical symptoms of cardiovascular conditions such as peripheral arterial disease, angina, coronary artery disease, cardiomyopathy, intermittent claudication, ischemic heart disease, atherosclerosis, and congestive heart failure.47-54 PLC appears to be more potent than L-carnitine in improving vascular function.55 PLC passes across the mitochondrial membrane to supply L-carnitine directly to the mitochondria, the energy-producing organelles of all cells. Carnitines are essential for mitochondrial fatty acid transport and energy production. This is important because heart muscle cells and endothelial cells burn fatty acids rather than glucose for 70% of their energy. By contrast, most cells generate 70% of their energy from glucose and only 30% from fatty acids.56 Carnitine deficiency has been associated with congestive heart failure.50 PLC supplementation has been reported to increase exercise capacity, optimize energy production, and reduce ventricular size in patients with congestive heart failure.50 The myocardium, the muscular substance of the heart, comprises cells called cardiomyocytes. A study of cardiomyocytes found that PLC helped to correct an imbalance between the production and utilization of adenosine triphosphate (ATP), the energy currency used throughout the body. This suggests that PLC may improve cardiac performance by improving energy metabolism and optimizing ATP levels.57 An animal study suggests PLC may help to prevent or decrease the severity of atherosclerosis. In rabbits fed a high-cholesterol diet, which normally induces endothelial dysfunction and subsequent atherosclerosis, supplementation with PLC resulted in reduced plaque thickness, markedly lower triglyceride levels, and reduced proliferation of foam cells, thereby preventing the progression of atherosclerosis.53 PLC has been shown to have a protective role against vascular cell inflammation that other carnitines do not. When rodents were exposed to irritating chemicals, PLC protected their vascular cells from this source of damage, but L-carnitine and acetyl-L-carnitine did not, leading the study authors to support “a specific protective role of PLC in the vascular component of the inflammatory process.”45 PLC improves endothelial function by increasing nitric oxide production in animals with normal blood pressure and in animal models of hypertension. The increased nitric oxide production induced by PLC is related to its antioxidant properties; PLC reduces reactive oxygen species and increases nitric oxide production in the endothelium in the presence of superoxide dismutase (SOD) and catalase.58 Oxygen-deprived endothelial cells produce large amounts of free radicals. Laboratory findings suggest that PLC protects these cells during periods of oxygen deprivation. When blood flow is restored, PLC also allows the cells to regain their lost energy charge much faster.46 An animal study indicates that PLC prevents abnormal heart muscle function associated with diabetes. The researchers found that PLC significantly increased both fatty acid and glucose utilization while restoring cardiac muscle function. These findings suggest PLC prevents diminished cardiac function associated with diabetes, possibly by promoting a favorable shift in glucose and fatty acid metabolism.59
PLC Improves Physical PerformanceIntermittent claudication is a condition caused by narrowing of the leg arteries. Patients typically experience pain in their calf muscles that makes walking long distances difficult or impossible. In a 24-week study, patients supplemented with PLC gradually increased the distance they were able to walk on a treadmill by up to 73%. The study authors concluded, “The response rate during the entire titration course was significantly in favor of [PLC] compared with placebo. Although the precise mode of therapeutic action requires clarification, [PLC], at a dose of 1000 mg to 2000 mg a day appears to be effective and well tolerated, with minimal adverse effects.”60 Several studies have shown that PLC increases the walking capacity of patients with peripheral arterial disease. A study comparing PLC to L-carnitine showed that PLC increased patient walking distance from 245 to 349 meters, while carnitine was only slightly better than placebo.55 Ultrasound testing found that PLC acts through a metabolic mechanism rather than by altering blood velocity or flow.55 Another study suggested that PLC increases muscle strength in patients with peripheral arterial disease.54 PLC and Male Sexual DysfunctionIn a study of male sexual dysfunction, testosterone supplementation was compared to supplementation with a combination of oral PLC and acetyl-L-carnitine. Both the carnitine combination and testosterone improved the following penile functions: peak systolic velocity, end-diastolic velocity, resistive index, nocturnal penile tumescence, and the International Index of Erectile Function score. The combination of 2 grams each of PLC and acetyl-L-carnitine daily was more effective than testosterone at improving nocturnal penile tumescence and the International Index of Erectile Function score, an important measure of erectile and sexual function. PLC and acetyl-L-carnitine thus appear to be safe, effective agents for managing male sexual dysfunction.42
PLC and Chronic FatigueIn a landmark study, researchers examined carnitine’s effects on patients with chronic fatigue syndrome. In this 24-week study, investigators followed three groups of 30 patients who supplemented daily with 2 grams of acetyl-L-carnitine, 2 grams of PLC, or a combination of the two. The results were remarkable: the clinical global impression of change after treatment improved significantly in 59% of the patients taking acetyl-L-carnitine and in 63% of patients taking PLC. While the main effect of acetyl-L-carnitine was improving mental fatigue, PLC helped to improve symptoms of general fatigue.43 Replenishing Cellular Energy StoresAdenosine triphosphate (ATP) is the primary molecule used by all human cells as energy currency. ATP is stored in the organs and red blood cells, but is especially concentrated in the liver. A study measuring ATP levels in human red blood cells found that people in their seventies had about 50% less ATP than young adults in their twenties.61 For 40 years, scientists have worked to create an effective, orally ingested form of ATP that is able to boost endogenous ATP levels. Five years ago, they developed an orally administered ATP that can effectively raise pools of ATP throughout the body.62-64 Orally administered ATP expands ATP in the liver, red blood cells, blood plasma, and organs. Supplemental ATP improves blood vessel tone and relaxes blood vessel walls, increasing blood flow to the lungs, heart, and peripheral areas without affecting heart rate or blood pressure.62-64 ATP supplementation can also elevate the body’s intracellular and extracellular stores of ATP, providing increased energy and improved athletic performance. Additionally, ATP supplementation enhances the delivery of glucose, nutrients, and oxygen to recovering and working muscles, while speeding the muscles’ removal of waste products. ATP benefits muscle growth, recovery, and strength, and lessens the perception of fatigue and exercise-associated pain.62 Supplementing with ATP helps to restore youthful levels of ATP in the body.62,63,65,66 Studies Confirm Benefits of PEAK ATP™The patented brand of ATP tested in numerous human and animal studies—PEAK ATP™—elevates red blood cell and plasma ATP levels, producing effects similar to those achieved by intravenous ATP administration.62-64 Studies show that PEAK ATP™ is readily absorbed, broken down into adenosine and organic phosphate, and incorporated in the liver and red blood cells to raise ATP pools. PEAK ATP™ boosts circulating ATP levels for at least six hours and should reach a steady-state plasma level within 24 hours.62-64 When administered orally to rabbits, ATP regulates and normalizes their cardiopulmonary functions, increasing blood flow, reducing overall vascular resistance, and increasing arterial oxygen pressure.65 In baboons, ATP infusions increased cerebral blood flow by nearly 50% and boosted oxygen consumption in the brain.65
During exercise, vascular blood flow increases due to the release of ATP into the blood. Infusing ATP into the legs of resting subjects increases blood flow in the thighs similar to that produced by exercise, suggesting that exogenously administered ATP may likewise promote increased circulation.66 Recent studies show that arterial and vein diameter is regulated by red blood cells sensing low blood oxygen levels. The red blood cells then release ATP, which produces endothelial vasodilation, or widening of the arteries. This mechanism of artery widening has been demonstrated in studies involving various species and tissues.67,68 Thus, red blood cells use ATP to help meet local tissue oxygen needs. Ensuring adequate red blood cell pools of ATP to help regulate vascular tone is now seen as critical to maintaining circulatory health.68 ATP release decreases with advancing age, which may be a cause of age-related increases in blood pressure. In fact, patients with primary pulmonary hypertension have been shown to suffer from impaired ATP release from red blood cells.69 This is also true of patients with cystic fibrosis who also develop pulmonary hypertension.70 Adenosine, a breakdown product of ATP, may act as an endogenous protector of the heart. Research suggests that through various chemical processes, adenosine may inhibit the damaging effects of ischemic heart disease and heart failure.71 Adenosine may increase coronary blood flow and alleviate the harmful effects of chronic heart failure.71 Adenosine is released from the heart primarily when the heart’s oxygen supply is limited as a result of increased oxygen consumption during exercise, restricted blood flow due to atherosclerosis, or ischemic events such as heart attack.71 Thus it is vitally important to maintain optimal levels of adenosine produced by the heart and arteries internally, as well as of adenosine supplied from external sources such as dietary plant and animal foods | ||||||
ConclusionAtherosclerosis remains the number-one cause of death and disability in the United States. The endothelial cells that line blood vessels are crucial to maintaining vascular integrity. Endothelial dysfunction is a critical factor in the initiation and progression of cardiovascular disease. Two natural compounds—propionyl-l-carnitine (PLC) and PEAK ATP™—offer promise in restoring and maintaining healthy endothelial function while supporting cellular energy metabolism. PLC provides energy to the heart and vascular cells by promoting optimal energy metabolism in the mitochondria. PEAK ATP™ boosts energy levels and vascular health by restoring youthful levels of ATP in red blood cells, tissues, and organs. Together, these two powerful compounds support optimal cellular energy and vascular health. |
| References |
| 1. Selnes OA, Grega MA, Borowicz LM, Jr., et al. Self-reported memory symptoms with coronary artery disease: a prospective study of CABG patients and nonsurgical controls. Cogn Behav Neurol. 2004 Sep;17(3):148-56. 2. Toner I, Peden CJ, Hamid SK, et al. Magnetic resonance imaging and neuropsychological changes after coronary artery bypass graft surgery: preliminary findings. J Neurosurg Anesthesiol. 1994 Jul;6(3):163-9. 3. Rasouli ML, Nasir K, Blumenthal RS, et al. Plasma homocysteine predicts progression of atherosclerosis. Atherosclerosis. 2005 Jul;181(1):159-65. 4. Xie LQ, Wang X. C-reactive protein and atherosclerosis. Sheng Li Ke Xue Jin Zhan. 2004 Apr;35(2):113-8. 5. Verma S. C-reactive protein incites atherosclerosis. Can J Cardiol. 2004 Aug;20 Suppl B29B-31B. 6. Stochmal E, Szurkowska M, Czarnecka D, et al. Association of coronary atherosclerosis with insulin resistance in patients with impaired glucose tolerance. Acta Cardiol. 2005 Jun;60(3):325-31. 7. Sharrett AR, Patsch W, Sorlie PD, et al. Associations of lipoprotein cholesterols, apolipoproteins A-I and B, and triglycerides with carotid atherosclerosis and coronary heart disease. The Atherosclerosis Risk in Communities (ARIC) Study. Arterioscler Thromb. 1994 Jul;14(7):1098-104. 8. Muis MJ, Bots ML, Bilo HJ, et al. High cumulative insulin exposure: a risk factor of atherosclerosis in type 1 diabetes? Atherosclerosis. 2005 Jul;181(1):185-92. 9. Malkin CJ, Pugh PJ, Jones RD, Jones TH, Channer KS. Testosterone as a protective factor against atherosclerosis—immunomodulation and influence upon plaque development and stability. J Endocrinol. 2003 Sep;178(3):373-80. 10. Howes PS, Zacharski LR, Sullivan J, Chow B. Role of stored iron in atherosclerosis. J Vasc Nurs. 2000 Dec;18(4):109-14. 11. Jones RD, Nettleship JE, Kapoor D, Jones HT, Channer KS. Testosterone and atherosclerosis in aging men: purported association and clinical implications. Am J Cardiovasc Drugs. 2005;5(3):141-54. 12. de Valk B, Marx JJ. Iron, atherosclerosis, and ischemic heart disease. Arch Intern Med. 1999 Jul 26;159(14):1542-8. 13. Drexel H, Amann FW, Beran J, et al. Plasma triglycerides and three lipoprotein cholesterol fractions are independent predictors of the extent of coronary atherosclerosis. Circulation. 1994 Nov;90(5):2230-5. 14. Chau LY. Iron and atherosclerosis. Proc Natl Sci Counc Repub China B. 2000 Oct;24(4):151-5. 15. Bolad I, Delafontaine P. Endothelial dysfunction: its role in hypertensive coronary disease. Curr Opin Cardiol. 2005 Jul;20(4):270-4. 16. Chakraphan D, Sridulyakul P, Thipakorn B, et al. Attenuation of endothelial dysfunction by exercise training in STZ-induced diabetic rats. Clin Hemorheol Microcirc. 2005;32(3):217-26. 17. Harvey PJ, Picton PE, Su WS, et al. Exercise as an alternative to oral estrogen for amelioration of endothelial dysfunction in postmenopausal women. Am Heart J. 2005 Feb;149(2):291-7. 18. Hink U, Tsilimingas N, Wendt M, Munzel T. Mechanisms underlying endothelial dysfunction in diabetes mellitus: therapeutic implications. Treat Endocrinol. 2003;2(5):293-304. 19. Lteif AA, Han K, Mather KJ. Obesity, insulin resistance, and the metabolic syndrome: determinants of endothelial dysfunction in whites and blacks. Circulation. 2005 Jul 5;112(1):32-8. 20. Newby DE, McLeod AL, Uren NG, et al. Impaired coronary tissue plasminogen activator release is associated with coronary atherosclerosis and cigarette smoking: direct link between endothelial dysfunction and atherothrombosis. Circulation. 2001 Apr 17;103(15):1936-41. 21. Panus C, Mota M, Vladu D, Vanghelie L, Raducanu CL. The endothelial dysfunction in diabetes mellitus. Rom J Intern Med. 2003;41(1):27-33. 22. Papamichael CM, Aznaouridis KA, Stamatelopoulos KS, et al. Endothelial dysfunction and type of cigarette smoked: the impact of ‘light’ versus regular cigarette smoking. Vasc Med. 2004 May;9(2):103-5. 23. Suvorava T, Lauer N, Kojda G. Physical inactivity causes endothelial dysfunction in healthy young mice. J Am Coll Cardiol. 2004 Sep 15;44(6):1320-7. 24. Toikka JO, Ahotupa M, Viikari JS, et al. Constantly low HDL-cholesterol concentration relates to endothelial dysfunction and increased in vivo LDL-oxidation in healthy young men. Atherosclerosis. 1999 Nov 1;147(1):133-8. 25. Vakkilainen J, Makimattila S, Seppala-Lindroos A, et al. Endothelial dysfunction in men with small LDL particles. Circulation. 2000 Aug 15;102(7):716-21. 26. Apetrei E, Ciobanu-Jurcut R, Rugina M, Gavrila A, Uscatescu V. C-reactive protein, prothrombotic imbalance and endothelial dysfunction in acute coronary syndromes without ST elevation. Rom J Intern Med. 2004;42(1):95-102. 27. Kunes P. C-reactive protein in the pathogenesis of atherosclerosis: advantage and pitfalls of the “Mainz hypothesis.” Cas Lek Cesk. 2005;144(1):25-31. 28. Targher G, Bertolini L, Zoppini G, Zenari L, Falezza G. Increased plasma markers of inflammation and endothelial dysfunction and their association with microvascular complications in Type 1 diabetic patients without clinically manifest macroangiopathy. Diabet Med. 2005 Aug;22(8):999-1004. 29. Sainani GS, Sainani R. Homocysteine and its role in the pathogenesis of atherosclerotic vascular disease. J Assoc Physicians India. 2002 May;50 Suppl16-23. 30. Drouet L, Bal dit SC. Is fibrinogen a predictor or a marker of the risk of cardiovascular events? Therapie. 2005 Mar;60(2):125-36. 31. Caballero AE, Arora S, Saouaf R, et al. Microvascular and macrovascular reactivity is reduced in subjects at risk for type 2 diabetes. Diabetes. 1999 Sep;48(9):1856-62. 32. Ceriello A. Hyperglycaemia: the bridge between non-enzymatic glycation and oxidative stress in the pathogenesis of diabetic complications. Diabetes Nutr Metab. 1999 Feb;12(1):42-6. 33. Cubeddu LX, Hoffmann IS. Insulin resistance and upper-normal glucose levels in hypertension: a review. J Hum Hypertens. 2002 Mar;16 Suppl 1S52-5. 34. Nowak A, Stankiewicz W, Szczesniak L, Korman E. Glucosamine in the blood serum of young people with diabetes mellitus type 1. Endokrynol Diabetol Chor Przemiany Materii Wieku Rozw. 1999;5(2):97-101. 35. Steinbaum SR. The metabolic syndrome: an emerging health epidemic in women. Prog Cardiovasc Dis. 2004 Jan;46(4):321-36. 36. Woodman RJ, Chew GT, Watts GF. Mechanisms, significance and treatment of vascular dysfunction in type 2 diabetes mellitus: focus on lipid-regulating therapy. Drugs. 2005;65(1):31-74. 37. Brandes RP, Fleming I, Busse R. Endothelial aging. Cardiovasc Res. 2005 May 1;66(2):286-94. 38. Kravchenko J, Goldschmidt-Clermont PJ, Powell T, et al. Endothelial progenitor cell therapy for atherosclerosis: the philosopher’s stone for an aging population? Sci Aging Knowledge Environ. 2005 Jun 22;2005(25):e18. 39. Rubanyi GM. The role of endothelium in cardiovascular homeostasis and diseases. J Cardiovasc Pharmacol. 1993;22 Suppl 4:S1-14. 40. Available at: http://www.medreviews.com/ pdfs/articles/RIU_5Suppl7_S21.pdf. Accessed April 20, 2005. 41. Available at: http://www.escardio.org/knowledge/cardiology_practice/ejournal_vol1/Vol1_no16.htm. Accessed April 20, 2005. 42. Cavallini G, Caracciolo S, Vitali G, Modenini F, Biagiotti G. Carnitine versus androgen administration in the treatment of sexual dysfunction, depressed mood, and fatigue associated with male aging. Urology. 2004 Apr;63(4):641-6. 43. Vermeulen RC, Scholte HR. Exploratory open label, randomized study of acetyl- and propionylcarnitine in chronic fatigue syndrome. Psychosom Med. 2004 Mar;66(2):276-82. 44. Bertelli A, Conte A, Ronca G, Segnini D, Yu G. Protective effect of propionyl carnitine against peroxidative damage to arterial endothelium membranes. Int J Tissue React. 1991;13(1):41-3. 45. Amico-Roxas M, Caruso A, Cutuli VM, de Bernardis E, Leonardi G. Inhibitory effects of propionyl-L-carnitine on plasma extravasation induced by irritants in rodents. Drugs Exp Clin Res. 1993;19(5):213-7. 46. Bertelli A, Conte A, Palmieri L, et al. Effect of propionyl carnitine on energy charge and adenine nucleotide content of cardiac endothelial cells during hypoxia. Int J Tissue React. 1991;13(1):37-40. 47. Wiseman LR, Brogden RN. Propionyl-L-carnitine. Drugs Aging. 1998 Mar;12(3):243-8. 48. Ferrari R, Merli E, Cicchitelli G, et al. Therapeutic effects of L-carnitine and propionyl-L-carnitine on cardiovascular diseases: a review. Ann NY Acad Sci. 2004 Nov;1033:79-91. 49. Hiatt WR. Carnitine and peripheral arterial disease. Ann NY Acad Sci. 2004 Nov;1033:92-8. 50. Anand I, Chandrashekhan Y, De Giuli F, et al. Acute and chronic effects of propionyl-L-carnitine on the hemodynamics, exercise capacity, and hormones in patients with congestive heart failure. Cardiovasc Drugs Ther. 1998 Jul;12(3):291-9. 51. Sayed-Ahmed MM, Salman TM, Gaballah HE, et al. Propionyl-L-carnitine as protector against adriamycin-induced cardiomyopathy. Pharmacol Res. 2001 Jun;43(6):513-20. 52. Bartels GL, Remme WJ, Pillay M, Schonfeld DH, Kruijssen DA. Effects of L-propionylcarnitine on ischemia-induced myocardial dysfunction in men with angina pectoris. Am J Cardiol. 1994 Jul 15;74(2):125-30. 53. Spagnoli LG, Orlandi A, Marino B, et al. Propionyl-L-carnitine prevents the progression of atherosclerotic lesions in aged hyperlipemic rabbits. Atherosclerosis. 1995 Apr 7;114(1):29-44. 54. Barker GA, Green S, Askew CD, Green AA, Walker PJ. Effect of propionyl-L-carnitine on exercise performance in peripheral arterial disease. Med Sci Sports Exerc. 2001 Sep;33(9):1415-22. 55. Brevetti G, Perna S, Sabba C, et al. Superiority of L-propionylcarnitine vs L-carnitine in improving walking capacity in patients with peripheral vascular disease: an acute, intravenous, double-blind, cross-over study. Eur Heart J. 1992 Feb;13(2):251-5. 56. Kaiser KP, Feinendegen LE. Planar scintigraphy versus PET in measuring fatty acid metabolism of the heart. Herz. 1987 Feb;12(1):41-50. 57. Torielli L, Conti F, Cinato E, et al. Alterations in energy metabolism of hypertrophied rat cardiomyocytes: influence of propionyl-L-carnitine. J Cardiovasc Pharmacol. 1995 Sep;26(3):372-80. 58. Bueno R, Alvarez de Sotomayor M, Perez-Guerrero C, et al. L-carnitine and propionyl-L-carnitine improve endothelial dysfunction in spontaneously hypertensive rats: Different participation of NO and COX-products. Life Sci. 2005 Jun 13. 59. Broderick TL, Haloftis G, Paulson DJ. L-propionylcarnitine enhancement of substrate oxidation and mitochondrial respiration in the diabetic rat heart. J Mol Cell Cardiol. 1996 Feb;28(2):331-40. 60. Brevetti G, Perna S, Sabba C, Martone VD, Condorelli M. Propionyl-L-carnitine in intermittent claudication: double-blind, placebo-controlled, dose titration, multicenter study. J Am Coll Cardiol. 1995 Nov 15;26(6):1411-16. 61. Rabini RA, Petruzzi E, Staffolani R, et al. Diabetes mellitus and subjects’ ageing: a study on the ATP content and ATP-related enzyme activities in human erythrocytes. Eur J Clin Invest. 1997 Apr;27(4):327-32. 62. Kichenin K, Decollogne S, Angignard J, Seman M. Cardiovascular and pulmonary response to oral administration of ATP in rabbits. J Appl Physiol. 2000 Jun;88(6):1962-8. 63. Kichenin K, Seman M. Chronic oral administration of ATP modulates nucleoside transport and purine metabolism in rats. J Pharmacol Exp Ther. 2000 Jul;294(1):126-33. 64. US patent 5,049,372. US patent 5,227,371. 65. Van Aken H, Puchstein C, Fitch W, Graham DI. Haemodynamic and cerebral effects of ATP-induced hypotension. Br J Anaesth. 1984 Dec;56(12):1409-16. 66. Rosenmeier JB, Hansen J, Gonzalez-Alonso J. Circulating ATP-induced vasodilatation overrides sympathetic vasoconstrictor activity in human skeletal muscle. J Physiol. 2004 Jul 1;558(Pt 1):351-65. 67. Gonzalez-Alonso J, Olsen DB, Saltin B. Erythrocyte and the regulation of human skeletal muscle blood flow and oxygen delivery: role of circulating ATP. Circ Res. 2002 Nov 29;91(11):1046-55. 68. Ellsworth ML, Forrester T, Ellis CG, Dietrich HH. The erythrocyte as a regulator of vascular tone. Am J Physiol. 1995 Dec;269(6 Pt 2):H2155-161. 69. Sprague RS, Stephenson AH, Ellsworth ML, Keller C, Lonigro AJ. Impaired release of ATP from red blood cells of humans with primary pulmonary hypertension. Exp Biol Med (Maywood.). 2001 May;226(5):434-9. 70. Sprague RS, Ellsworth ML, Stephenson AH, Kleinhenz ME, Lonigro AJ. Deformation-induced ATP release from red blood cells requires CFTR activity. Am J Physiol. 1998 Nov;275(5 Pt 2):H1726-32. 71. Kitakaze M, Minamino T, Node K, et al. Adenosine and cardioprotection in the diseased heart. Jpn Circ J. 1999 Apr;63(4):231-43. |